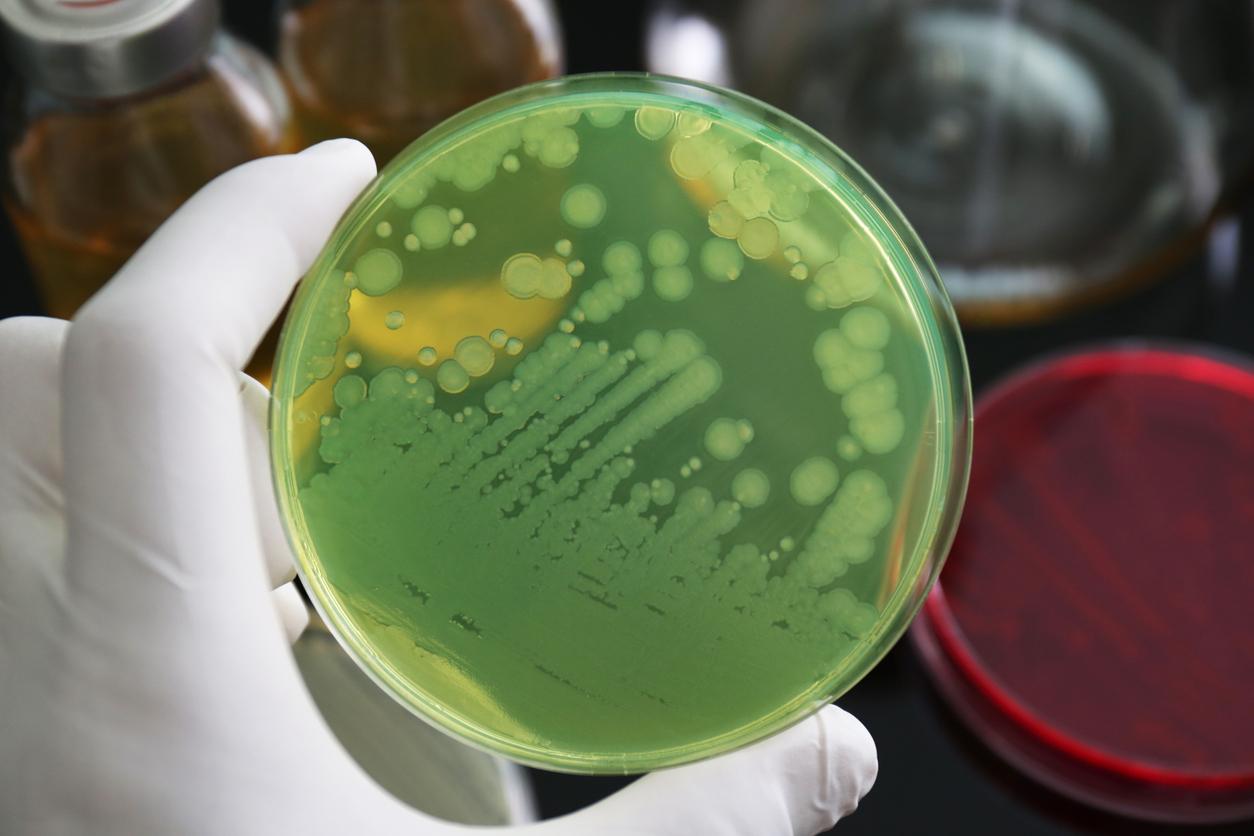

Des "super bactéries" qui résistent aux antibiotiques les plus puissants : voici l’une des menaces sanitaires qui plane aujourd’hui sur l’humanité.
Déjà responsable de 33 000 décès par an au sein de l’Union européenne, la résistance aux anti-microbiens pourrait, selon un rapport datant de 2014, atteindre 10 millions de morts par an chaque année en 2050.
Parmi ces bactéries potentiellement mortelles et ayant développé une multirésistance aux antibiotiques se trouve Pseudomonas aeruginosa. Considérée par l’Organisation mondiale de la Santé (OMS) comme l’un des agents pathogènes les plus dangereux, elle est particulièrement présente dans les milieux hospitaliers, où elle est susceptible de causer des infections sanguines et des pneumonies chez les personnes dont le système immunitaire est affaibli.
Sa particularité : comme d’autres "super bactéries", elle sécrète une protéine appelée HasA qui s’accroche au système d’acquisition de l’hème présent dans le sang de son hôte. Cela lui permet d’obtenir du fer, un oligo-élément essentiel à sa croissance. Ce complexe de la sécrétion de la protéine HasA est reconnu par un récepteur membranaire de la bactérie appelé HasR, qui permet l'entrée de l'hème dans la cellule bactérienne, tandis que la protéine HasA est recyclée pour récupérer davantage de fer.
Un "cheval de Troie" qui détruit les bactéries de l’intérieur
Toutefois, ce mécanisme pourrait être détourné. C’est ce que sont parvenus à faire des chercheurs de l’Université de Nagoya, au Japon. Dans une étude publiée en ligne sur ACS Chemical Biology, ils expliquent être parvenus tuer les bactéries Pseudomonas aeruginosa en détournant leur système d'acquisition de l'hème, ce qui leur a permis de leur administrer des antimicrobiens.
Pour y parvenir, ils ont mis au point une poudre formée de la protéine HasA et d’un pigment phtalocyanine de gallium (GaPc) qui, appliqué à une culture de Pseudomonas aeruginosa, a été consommé par les bactéries.
"Lorsque le pigment est exposé à la lumière proche infrarouge, des espèces d'oxygène réactif nocives sont générées à l'intérieur des cellules bactériennes", explique Osami Shoji, auteur principal des travaux. Lors des tests, plus de 99,99 % des bactéries ont ainsi été tuées grâce à ce traitement et à dix minutes d'irradiation.
La stratégie a également fonctionné sur d'autres bactéries avec le récepteur HasR sur leurs membranes, expliquent les chercheurs.
"Nos résultats appuient l'utilisation de protéines d'hème artificielles comme cheval de Troie pour administrer sélectivement des antimicrobiens à des bactéries cibles, permettant leur stérilisation spécifique et efficace, indépendamment de la résistance aux antibiotiques ", rapporte l'équipe dans son étude, qui espère que cette stratégie pourra fonctionner sur d’autres bactéries multirésistantes.